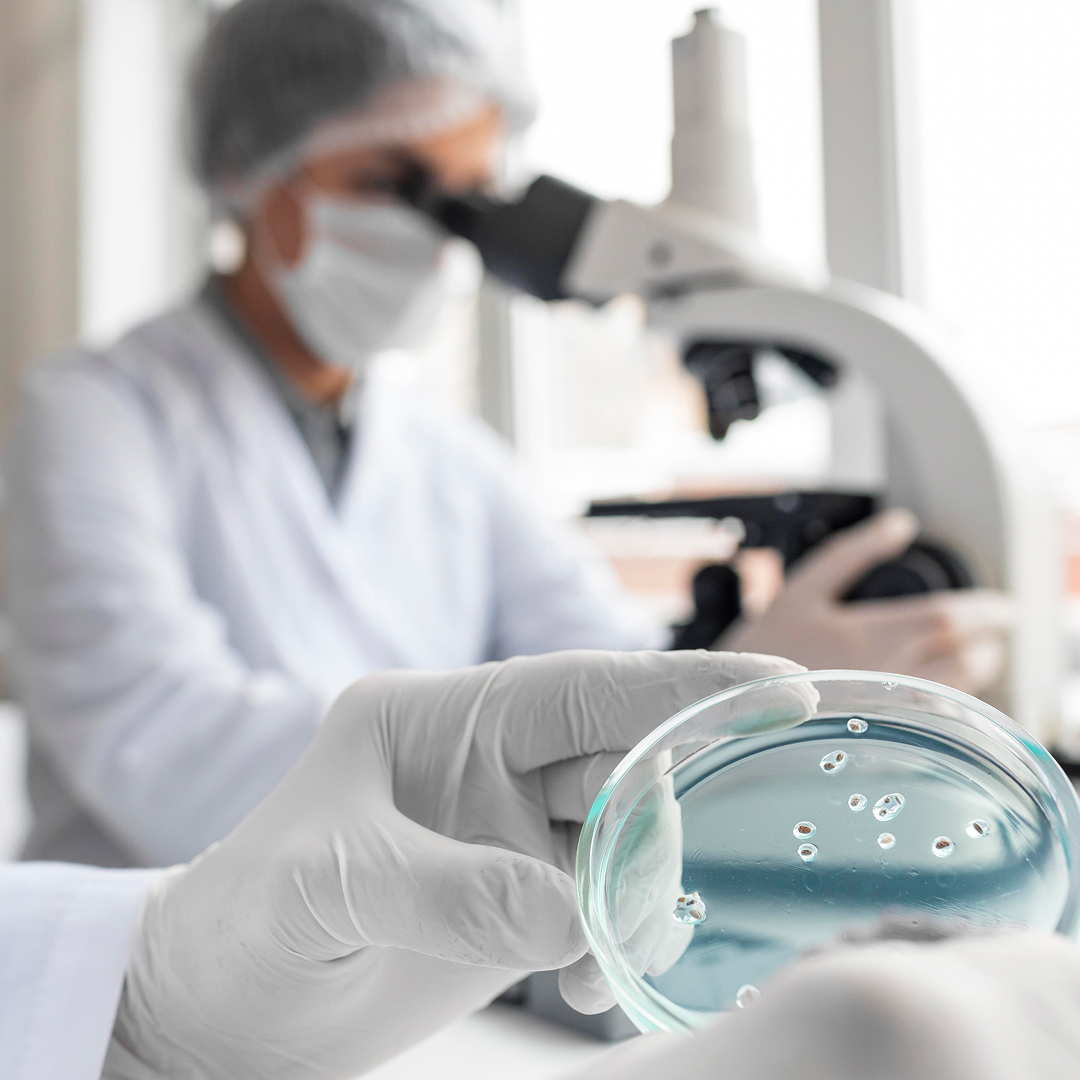

Standardy IRiBS™
Standardy i rozwiązania IRiBS™
IRiBS™ stworzył własne standardy jakości w odpowiedzi na realne problemy rynku suplementów diety.
W praktyce często spotyka się produkty o podobnym składzie, które znacząco różnią się jakością, stabilnością i przewidywalnością działania. Źródłem tych różnic rzadko jest pojedynczy składnik — znacznie częściej są nim decyzje podejmowane na etapie pracy z surowcem, doboru technologii oraz projektowania formulacji.
Wiele kluczowych elementów jakości pozostaje dziś niewidocznych dla konsumenta i niesformalizowanych po stronie producenta. Brakuje jasnych ram, które pozwalałyby odróżnić produkt zaprojektowany świadomie od produktu powstałego w oparciu o uproszczenia technologiczne lub kompromisy kosztowe.

Standard AQS™
Highest Herbs Potential
Dlatego IRiBS™ opracował dwa komplementarne standardy jakości. Pierwszym z nich jest HHP™ – Highest Herbs Potential, czyli standard pracy z surowcami roślinnymi, który porządkuje sposób ekstrakcji i maceracji w oparciu o biologię roślin, ich zmienność oraz miejsce koncentracji substancji aktywnych. HHP™ zakłada indywidualne dopasowanie procesu do surowca, zamiast stosowania jednego, uniwersalnego schematu technologicznego.
-
Uporządkowany sposób pracy z surowcami roślinnymi
-
Realne argumenty jakościowe oparte na procesie


Standard AQS™
Advanced Quality System
Drugim standardem jest AQS™ – Advanced Quality System, który dotyczy projektowania i kontroli jakości gotowych suplementów diety. AQS™ koncentruje się na stabilności formulacji, czystości surowców, powtarzalności partii oraz spójności produktu w czasie, tak aby suplement zachowywał swoją jakość nie tylko w momencie produkcji, ale również w długofalowej perspektywie.
-
Ustandaryzowany proces projektowania formulacji
-
Mniejsze ryzyko degradacji wrażliwych związków


Why choose us
Unmatched global payroll expertise
Seamless payroll solutions. Expertise, reliability, and professioanl support for your business and corporate needs.